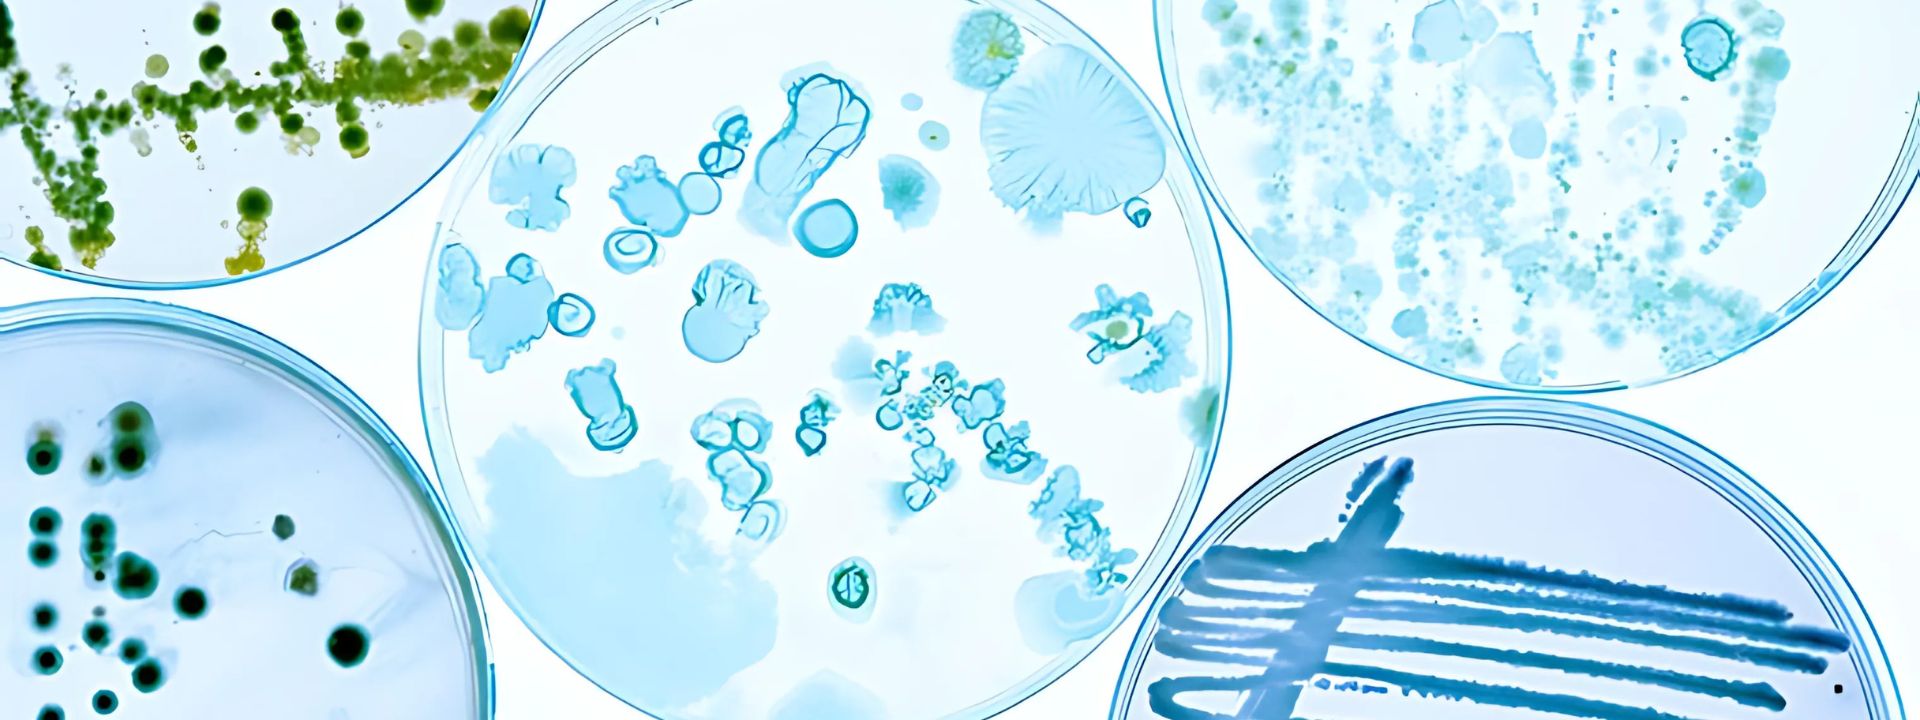

Analyses microbiologique
Le réseau de laboratoires Eurofins propose une gamme complète de services d'analyses microbiologiques conçus pour vous aider à vérifier la sécurité alimentaire, répondre aux exigences réglementaires et garantir la qualité sanitaire de vos produits.
Analyses microbiologiques accréditées avec des délais de traitement rapides.
Nos laboratoires accrédités ISO 17025 offrent des analyses à haut débit avec des délais de traitement rapides*. Nous accompagnons les fabricants, les distributeurs et les acteurs de la restauration grâce à une expertise en analyses microbiologiques, conforme aux réglementations de l’Union européenne, aux normes de l’industrie et aux spécifications propres à chaque client.
Méthodes d’analyse flexibles pour répondre à vos besoins.
Notre portefeuille complet comprend :
- Des méthodes normalisées ISO et des méthodes de référence nationales
- Des alternatives rapides et validées (par exemple, PCR et milieux chromogènes), permettant d’obtenir des résultats en 24 heures* pour les détections négatives de pathogènes — idéal pour les tests de libération de produits
Techniques avancées pour l’identification des causes profondes.
Grâce à nos investissements continus en R&D, nous pouvons vous accompagner avec des outils microbiologiques avancés pour analyser les organismes de dégradation et les sources de contamination. En utilisant des techniques telles que la NGS-PCR (séquençage de nouvelle génération basé sur la PCR) et la NGS-WGS (séquençage du génome complet), nous vous aidons à retracer les flux de contamination, identifier des pathogènes spécifiques et renforcer vos systèmes de gestion de la sécurité alimentaire.
Détection des agents pathogènes et des toxines d’origine alimentaire.
Nos services d’analyses microbiologiques permettent de détecter et d’identifier un large éventail de micro-organismes pathogènes (pathogènes) et leurs toxines, notamment :
- Listeria monocytogenes
- Espèces de Salmonella
- Legionella pneumophila
- Escherichia coli (E. coli), y compris la souche O157
- Espèces de Vibrio
- Cronobacter (anciennement Enterobacter) sakazakii
- Clostridium perfringens
- Bacillus cereus
- Campylobacter
- Entérotoxines
- Staphylococcus aureus
- Yersinia enterocolitica
- Virus alimentaire
Nous proposons également des analyses accréditées pour les sous-produits animaux et les aliments pour animaux de compagnie.
Analyses microbiologiques pour soutenir le contrôle de la sécurité alimentaire
Le réseau de laboratoires et d’experts en microbiologie d’Eurofins propose à ses clients :
- Un portefeuille complet de techniques d’analyse microbiologique
- Des services d’analyses de haute qualité et fiables, reconnus par les clients et confirmés par de nombreux audits chaque année
- Une transmission électronique des résultats avec des outils intégrés pour l’analyse des tendances et les rapports statistiques
- Des conseils d’experts pour vous aider à interpréter les résultats et prendre des décisions éclairées
- Un service rapide et réactif assuré par des professionnels expérimentés en microbiologie
Formation
Si vous souhaitez en savoir plus sur la microbiologie alimentaire, consultez nos formations.
Remarque : nous développons en permanence de nouvelles méthodologies pour répondre aux besoins évolutifs. Pour connaître les délais d’exécution des analyses microbiologiques spécialisées, veuillez contacter votre laboratoire Eurofins local. Certains services sont proposés localement, tandis que d’autres peuvent être assurés par notre réseau de Centres de Compétence Eurofins.
Contactez-nous
Vous souhaitez en savoir plus sur nos solutions d’analyses ou vous avez besoin d'une assistance analytique personnalisée ? Contactez-nous dès aujourd'hui pour entrer en contact avec nos experts.